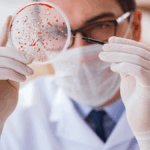

El programa ‘Héroes anónimos’ dedica su último espacio a la esclerosis múltiple

El televisivo dice adiós a los espectadores de Castilla-La Mancha hasta la próxima temporada que el equipo liderado por el periodista Julián Cano está ya preparando
Con motivo de la celebración el lunes 18 de diciembre del Día Nacional de la Esclerosis múltiple, ‘Héroes Anónimos’ dedica este domingo el último programa de la temporada número 16 a esta enfermedad que afecta a 55.000 personas en el país.
Bajo el título Esclerosis múltiple, la ciencia como esperanza se pondrá en valor el trabajo que realiza el equipo de neuroinmuno-reparación del Hospital Nacional de Parapléjicos de Toledo, grupo de referencia a nivel nacional, en la búsqueda de nuevos fármacos y una posible cura, ha informado la televisión regional en nota de prensa.
Una vez más se pone de manifiesto la importancia de la ciencia para erradicar este tipo de enfermedades. Y es que sin investigación, no hay futuro.
De esta manera, Héroes Anónimos dice adiós a los espectadores de Castilla-La Mancha Media hasta la próxima temporada que el equipo liderado por el periodista Julián Cano está ya preparando.
El programa se ha convertido en un referente de la radiotelevisión regional, demostrando su vocación de servicio público. Un total de 202 episodios emitidos y más de 2.500 historias de héroes y heroínas que ayudan a construir una mejor sociedad castellanomanchega.
Además, el mismo domingo 17, Cano recogerá el galardón Mi Voz por Tu Sonrisa a la Soliaridad que reconoce su labor y que se entregará en la Gala Benéfica Mi Voz por Tu Sonrisa Sin Etiquetas en el Teatro Buero Vallejo de Guadalajara.
Un premio que se suma a los cuarenta anteriores conseguidos a lo largo de su historia y entre los que destacan el Premio Iris de la Academia de la Televisión al mejor programa de televisiones autonómicas 2021, Premio Fundación Telefónica 2018, Premio Fundación Aliados 2020, Premio CASER 2020, Premio Supercuidadores 2018, 2019 y 2022, Premio Albert Jovel 2019, el Premio GEPAC 2021 y reconocimientos de los Gobiernos de Aragón, Melilla y Castilla-La Mancha.